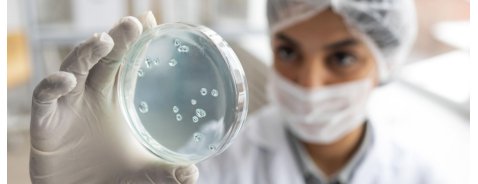
Akkermansia Muciniphila, il batterio alleato della salute

Akkermansia Muciniphila, il batterio alleato della salute
Si tratta di un microrganismo che si distingue per la sua abilità nel degradare la mucina intestinal...
Dieta a basso contenuto di colesterolo: ecco cosa mangiare
Il colesterolo è una sostanza lipidica fondamentale per l'organismo...
Quali sono i migliori integratori per le articolazioni?
Gli integratori per le articolazioni possono svolgere un ruolo chiave nel sostenere la funzionalità...
Cosa mangiare quando si ha il ferro basso?
Il ferro è un elemento fondamentale per numerose funzioni fisiologiche...
Qual è il miglior lassativo naturale?
Il primo passo per contrastare la stipsi ostinata è intervenire sull’alimentazione quotidiana...
.png)